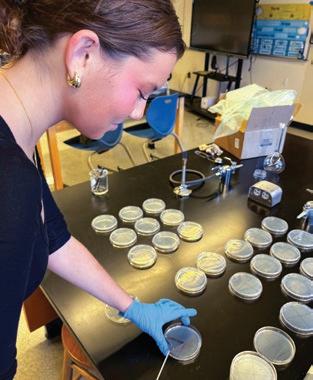

Falmouth Academy
38TH ANNUAL SCIENCE AND ENGINEERING FAIR
FEBRUARY 20, 2026
SCHEDULE OF EVENTS
8:15 ....................Students Set Up
8:30 ...................Orientation for Judges
9:00-12:00 .........Judging of Projects
11:30-1:00 ...........Judges and Faculty Lunch
12:00-1:00 ..........Class Lunches
12:30-3:00 ..........Extended Inquiry Showcase
3:00 ...................Public Viewing
3:15 ....................Buses Pick Up from MV Ferry
3:50 ...................Awards Ceremony
4:40 ...................Buses to MV Ferry
4:45 ...................Regular Buses Depart
ABOUT
THE SCIENCE FAIR LOGO
The original Falmouth Academy Science Fair logo was a linoleum cut designed by Ira Carmel ’89 on the occasion of FA’s inaugural science fair, held on March 17, 1989. The logo was refreshed in celebration of the 30th anniversary of the Fair, but retains its original whimsical representation of the depth and breadth of the research that is conducted by our students. Whether exploring the basic elements of life or building better rockets, our students’ curiosity about the world around them is reflected in this logo and in all the work presented.
SCIENCE AND ENGINEERING FAIR SPONSORS
LEGACY SPONSORS
Marine Biological Laboratory
Salt Pond Areas Bird Sanctuaries, Inc.
Sea Education Association
Woods Hole Oceanographic Institution
Woodwell Climate Research Center
NEWTON SIGNATURE SPONSOR
Scott Wayne
EDISON SPONSORS
Cazeault Roofing & Solar
Martha’s Vineyard Bank
McLane Research Laboratories, Inc.
Notus Clean Energy, LLC
Teledyne Marine
CURIE SPONSORS
Ament Endowed Fund for Science
Dalpe Excavation
Falmouth Water Stewards
Landschop Landscape Architecture
Lowell Instruments, LLC
MIT Club of Cape Cod
MARCONI SPONSORS
The 300 Committee Land Trust
Associates of Cape Cod
Dr. Scott Brown ’89 and Ms. Melissa Hofer
Sophie Markovich, DMD Family Orthodontics
Sports Center Physical Therapy
The Stillman Family
ARCHIMEDES SPONSORS
Bruce & Shirley Gordon Giving Fund
Hutker Architects, Inc.
IN-KIND VENDORS
Coffee Obsession
Devour Eatery
PrintSynergy
True North Event Rentals
On the cover: Falmouth Academy seventh-grade science students conduct science at sea, courtesy of the Zephyr Education Foundation.
WELCOME

Welcome to Falmouth Academy and our 38th Science & Engineering Fair! This event marks the culmination of five months of independent, hands-on scientific inquiry undertaken by every Falmouth Academy student in grades 7 through 10, with many juniors and seniors choosing to participate as well. Today’s presentations reflect not only the curiosity, persistence, and creativity of our students, but also the extraordinary dedication of our science faculty, who have guided and supported this work every step of the way.
The Science & Engineering Fair is a defining element of a Falmouth Academy education. In a world that is rapidly changing—where future careers may not yet exist and the challenges ahead are still taking shape—our students must learn how to ask meaningful questions, think critically, and pursue innovative solutions. This research experience is intentionally designed to cultivate those skills, which are among the most enduring and essential outcomes of an FA education.
As we celebrate the accomplishments on display today, we also recognize the community that makes this event possible. We extend special thanks to our faculty, who devote countless hours to mentoring students through setbacks, revisions, and breakthroughs. We are also deeply grateful to our mentors, judges, sponsors, and partners for the time, expertise, and generosity they bring to this day. Finally, we thank our families for their encouragement and support throughout the research process. Your collective commitment transforms this annual event into a powerful and memorable experience for our students. Thank you for being part of it.

When a student chooses a science fair topic that excites them, memorable moments abound: devising a question of genuine interest and then designing a feasible method. Then comes experimentation, and those first precious data points. Filling an empty table with data is immensely satisfying. Do the results support the hypothesis? With critical thinking hats on, students analyze their data and uncover the story of their results. While those first discoveries are thrilling, the pinnacle is standing at their board, ready to explain and defend their research to an expert.
Students discover a confidence that can only be earned through experience. Confidence in their abilities and in themselves. Improving year after year, students realize that they can present ideas clearly and succinctly, and communicate effectively with a future supervisor or broader audiences. These skills are powerful.
With a scientific foundation, students can assess information more fully and independently: questioning whether research supports its conclusions with an adequate sample size, meaningful variability, and peer-reviewed credibility. The ability to identify a high-quality study (or recognize a weak one) is essential for forming informed opinions. At a time when skepticism about science is growing and the scientific enterprise is undergoing significant change, scientific literacy is more important than ever. Educating the next generation to understand the quality, integrity, and societal value of scientific research matters.
It is through your encouragement that these students are able to grow into thoughtful, informed individuals who understand science, and how to evaluate it. Your support makes a difference not only to each student, but also to our broader scientific community.
David Perry Head of School


Liza Fox ’96 Science and Engineering Fair Coordinator
2026 SCIENCE AND ENGINEERING FAIR | JUDGES
Dr. Lisa Abbo MBL, Veterinarian and Staff Scientist
Mr. Philip Alatalo WHOI, Research Associate
Mr. David Aubrey ’26 Falmouth Academy, Student
Mr. Kyle Benton ’12 EPAM Continuum, Senior Innovation Consultant, Medical Engineering
Ms. Nell Bowen ’19 MBL, Research Assistant I
Dr. Scott Brown ’89 Rochester Institute of Technology, Principal Scientist
Mr. Brian Buczkowski USGS, Supervisory Physical Scientist
Ms. Kendra Buresch MBL, Lab Manager, Hanlon Lab
Mr. Rich Caruso INTER/COMP LLC, CEO
Ms. Elise Casso ’26 Falmouth Academy, Student
Dr. Victoria Centurino WHOI, Education Coordinator, Center for Chemical Currencies of a Microbial Planet
Ms. Antonie Chute NOAA NMFS (retired)
Ms. Sara Cook ’26 Falmouth Academy, Student
Dr. Allisa Dalpe ’12 WHOI, Research Engineer
Ms. Jayne DiCandio WBNERR, School and Interpretive Program Coordinator
Dr. Carol DiFalco Quincy College, Professor of Psychology
Ms. Jessica Donohue MBL, Lab Manager
Mr. Max Donovan ’26 Falmouth Academy, Student
Dr. Evie Fachon WHOI, PhD Student
Dr. Sofia Gabriel ’11 University of Tasmania, PhD Candidate
Dr. Stefan Gabriel Johnson & Johnson Mitek Sports Medicine, Principal Engineer, R&D
Dr. Elizabeth Gladfelter WHOI, Guest Investigator
Ms. Taleena Gonneea ’26 Falmouth Academy, Student
Ms. Kirsty Goode Normandeau Associates, Inc., Marine Scientist
Dr. Mark Hahn WHOI, Senior Scientist
Dr. Gregory Hinkle Alnylam Pharmaceuticals, VP, Research Informatics
Miss Julia Holtzer MBL, Research Assistant II
Dr. Peter Hopewood Cape Cod Surgeons, Surgeon
Dr. Jeff Hughes Wellesley College, Lecturer (retired)
Ms. Jillian Igoe ’18 MBL, Research Assistant II
Dr. Josef Kellndorfer Earth Big Data LLC, President
Dr. Preston Kemeny WHOI, Assistant Scientist
Ms. Sarah Kerr ’19 MBL, Research Assistant
Ms. Jessica Kozik WHOI, Senior Engineering Assistant I
Mrs. Sharon Kreamer Falmouth Academy, Teacher (retired)
Dr. Alan M. Kuzirian MBL, Senior Scientist, Emeritus
Ms. Willow Lajoie ’26 Falmouth Academy, Student
Mr. Nick Lowell ’88 Lowell Instruments LLC
Ms. Marinna Martini NOAA NEFSC, Engineer
Dr. Anna Michel WHOI, Associate Scientist
2026 SCIENCE AND ENGINEERING FAIR | JUDGES
Mrs. Maureen Nolan Teacher (retired)
Ms. Jin-Si Over USGS, Geographer
Mr. Charles Perry McLane Research Laboratories, Electro-mechanical Technician
Ms. Nico Pingal ’16 Savvas Learning Company LLC
Dr. James Preisig JPAnalytics, President
Mr. Rob Reynolds Zephyr Education Foundation, President
Mr. Robert Ronan ’26 Falmouth Academy, Student
Ms. Dhara Sananikone ’26 Falmouth Academy, Student
Mr. David Santamauro Fairview Research LLC, IFI CLAIMS Patent Services
Mr. Jared Schwartz ’03 WHOI, Research Engineer
Dr. Melissa Soule WHOI, Research Specialist
Ms. Chloe Starr ’04 Aquacultural Research Corporation, Operations Manager
Dr. Alan Steinbach Physician (retired)
Mrs. Mel Stephen Plymouth Public Schools, Physics Teacher (retired)
Dr. Bill Waite USGS, Geophysicist
Dr. Nancy Walbek (retired)
Dr. Mary Wallingford MBL, Research Scientist
Dr. Rylie Walsh
MBL, Imaging Specialist
Dr. Kerry Walton NYU School of Medicine, Professor (retired)
Mr. Scott Wayne (retired)
Mr. JC Weber MBL, Senior Research Assistant
Dr. Jens Wira MBL, Postdoctoral Scientist
Dr. Julia Zeh NOAA, Biologist
Dr. Andrew Zimmerman MGH & UMass, Pediatric Neurologist (retired)
MBL Marine Biological Laboratory
NEFSC / Northeast Fisheries Science Center, NMFS / National Marine Fisheries Service, NOAA National Oceanic and Atmospheric Administration
USGS United States Geological Survey
WBNERR Waquoit Bay National Estuarine Research Reserve
WHOI Woods Hole Oceanographic Institution
THANK YOU | 2026 MENTORS AND ADVISORS
Dr. Neel Aluru, WHOI
Dr. Alfredo Aretxabaleta, USGS
Dr. Nicholas Chaloux, WHOI
Dr. Allisa Dalpe ’12, WHOI
Dr. Jared Goldstone, WHOI
Chase Gray, WHOI
Dr. Mark Hahn, WHOI
Dr. Kirstin Meyer-Kaiser, WHOI
Dr. Christopher Sherwood, USGS
Dr. Tessa Steiniche, WHOI
EXHIBITORS & PROJECTS | MIDDLE SCHOOL (GRADES 7-8)
Alexander Abbo What Wing Shape Generates the Most Lift?
Jamie Allen How Do Energy Drinks Affect Heart Rate?
Kai Aretxabaleta Comparing the Durability of Bridges Over the Cape Cod Canal
Esmée Bush The Effects of Taurine on the Heart Rate of Daphnia magna
Cruz Cancellare Do Snakes Shed Better in a Moist or Dry Environment?
Alexander Chmelev Which Type of Cup Material Will Keep a Hot Drink the Warmest?
Catherine Connelly The Difference That a Fire Protectant Can Make
Prem Connor A Mathematical Model of PFAS Removal by Reverse Osmosis
Mayumi Cullinane Are There Benefits to Insulating Bee Hives?
Oliver Dube How Does Weather Affect the Production of Solar Energy?
Harrod Field How Much EMF Do Our Everyday Devices Emit?
Matthew Forcier Do Different Soccer Balls Affect the Bounce Height?
Nathan Forcier How Do Golf Ball Brands Compare in Flight Distance?
Emma Forend Can Plants Grow in Different Directions?
Josephine Gautier The Effect of Different Environments on the Oxidation of Metals
Wesley Greendeer Which Material Best Prevents Glacier Melting?
Christopher Greene, Jr. Which Angle Is the Best for a Balloon Powered Car?
Anna Gulmann How Does Temperature Affect an Oyster’s Consumption of Microplastics?
Nathalie Hershfield How Age Affects Hearing
Tyler Holmes Which Martial Arts Strike Has the Most Force?
Niamh Cullinane Correlation Between Octopus Size and Color Changing Abilities
Dean Kalkanis Red Light Therapy vs. Phone Scrolling: The Sleep Showdown
Katarina Kalkanis Can Exercise Really Make Your Brain Work Better?



EXHIBITORS & PROJECTS | MIDDLE SCHOOL (GRADES 7-8)
Jackson Keith Does Color Affect Perceived Sweetness?
Elliot Klein Which Gear Ratio Is Better for a Wheelie?
Ailsa Kluckhuhn How Different Variables Affect the Quality and Amount of Sleep
Avan Laird The Impact of Dogs on Families
Elise Laird Does Having a Twin Affect Your Personality?
Brogan Leary The Effect of Relatedness on Fingerprint Patterns
Jack Lerner How Much Water Does a Boat Displace Before It Sinks?
Thomas Louderback Do the Amount of Coils in an Electromagnet Affect the EMF Output?
Luca Mason The Effect of Paper Plane Wing Length on Distance Flown
Ashlyn McGettrick What Happens to Marine Shells When the Ocean Turns Acidic?
Brynne McGettrick What Type of Preservative Inhibits Bacterial Growth the Most?
Cora McNeany Which Sense Is Strongest?
Alessia Mezzacappa Is Seaweed the Future of Sustainable Fabric?
Elin Mogul How Temperature Affects Current Velocity
Jackson Murchison Durability of Fishing Lines in Different Marine Environments
Violette Najarian Do the Opinions of Others Influence Us More Than We Think?
Olive Nelson How Does pH Affect Flowers in a Vase?
Sumaiya Noury Using Artificial Intelligence to Detect Abnormalities in Blood Cells
Mabel O’Connor How Music Affects Goldendoodle Behavior
Grace O’Hanlon The Effects of Different Building Materials on Floods
Kazmira Pedler The Hatching Rate of Brine Shrimp in Different Water Temperatures
Sophie Perry Sugars’ Effect on Cognitive Ability
Beckham Peterson Protein Intake and Physiological Recovery in an Adolescent Male Dancer

EXHIBITORS & PROJECTS | MIDDLE SCHOOL (GRADES 7-8)
Weetamo Pocknett Effect of Different Awareness Campaigns on Prevention of Tick Disease
Phineas Schrader Effects of Music on 8th Graders’ Heart Rates
Cordelia Sciortino From Seed to Symphony: How Music Affects Plant Growth
David Soule What’s in the Deep: Morphology and Macrofauna at Deep Sea Mining Sites
Araminta Stevens The Effect of Oil Pollution on Artemia salina
Lulu Strickland How Temperature Affects the Growth of Sugar Crystals
Emerson Takach The Effect of Different pH Levels on Growth of a Zinnia Flower
Nina Teles Which Marker Re-Inks the Best?
William Tran How Does Bottle Size Affect the Creation of Elephant Toothpaste?
Lochlan Tyrrell-Evans The Effect of Architectural Design on Temperature
James Vincent Can You Taste Without Seeing or Smelling?
YoungJae Wagner How Water Depth Affects Wave Velocity
Tiberius H. Wallingford Simulating the Physics of Lightning
Brearley Ward Does Pond Shoreline Development Affect Duck Biodiversity
Declan Welch Recycled Oyster Shells: A Sustainable Way to Improve Water for Plants?
Reese Williams How Humidity Affects Blue Oyster Mushroom Growth
Kai Yung Is the “5 Second Rule” True or False?
Jay Zhang Energy Use of Different PC Applications
Cameron Zuluaga Do Hydroponics Improve Plant Growth?



EXHIBITORS & PROJECTS | UPPER SCHOOL (GRADES 9-12)
Alanna Andrews Effects of Natural Supplements on Yeast Respiration
Ari Aretxabaleta and Is CO2 Electrochemical Reduction a Solution for the Future?
Alden Bank
Sofia Canelos The Effect of Microplastics on Lemna minor
Emme Carroll The Effect of Changing Seasons on Procambarus acutus acutus Population
Yulin Chen Light and Life: How Different Types of Light Affect Ghost Shrimp
Elijah Coughlin Comparing Electrolytes in Energy Drinks and Regular Drinks
Mason Crowley and How Different Materials Affect Sound Absorption in Acoustic Boxes
Tama Tiapula
Ace Cugini Effects of Honey on the Properties of Watercolor Paint
Mira Davis and The Effect of Coastal Roughness on Wave Energy
Sophia Famely
Cassie Duarte The Difference in Durability of Different Kinds of Leather
Arianna Ebanks A Hydroponic System Incorporating Controlled Salinity
Cassidy Eldredge Exploring Material Decomposition Under Different Conditions
Bradley Forcier How Ballot Order Can Affect Voter Behavior
Veronica Foureman Study of Synergistic Antimicrobial Activity of Marine Terpenoids
Samuel Giguere Turning Mechanical Stress Into Energy
Adelina S. Greco Can Concussion Recovery Rates Be Predicted by Open AI Models?
Aliyha Holder Can Leading Questions Influence Eyewitness Testimony?
Magdalena Jazo The Effect of Culture Methods on Chemical Release from MSCs
Sydney Jeffcote Harbor Water Runoff Before and After a Storm
Giulia King The Effect of Color on Bird Behavior
Jack Leach Macroinvertebrates as Identifiers of Pollution



Samuel McGuire
Noah Moore
Finley Muric
Building Design Impact on the Ability to Survive an Earthquake
Effect of Sea Surface Temperature on Cetacean and Sea Turtle Strandings
What Drinks Erode Teeth the Most?
Nadalia Najarian Effects of Doodling on Academic Performance
Tatum Nelson
Hollis Oliver
Hannah Park
Sylvie Parsons
Maverick Pil
Ava Rickard
Ryan Ronan
Luke Seston
Owen Seston
Felix Shannon
The Effects of Magnets on the Germination Rate of Daikon Radishes
Enzymatic Degradation of Colored PET by Ideonella sakaiensis
The Age Dependent Effects of Nicotine on C. elegans
The Effect of Heavy Metals and Microplastic Pollution on Ulva lactuca
Benthic Microbial Fuel Cells (BMFCs): Key to the Deep Sea
How Much Force Can Different Shapes of Gourds Withstand
Inverse Filtration of RIRs Identified by Adaptive Filters
The Effects of Standing and Botox on Popliteal Angle
The Effect of Soil Composition Mixtures on Water Retention on Cape Cod
Examining Ferrofluidic Spike Count Compared to Distance From a Magnet
Charlotte Silveira Determining How Yeast Reacts With Organic vs. Non-Organic Fruits
Mary Snell
Siana Solarazza
Mira Street
Olivia Tanionos
Zara Taylor-Keefer
Avery Todd-Weinstein
Nolan Van Keuren
Building an ROV to Survey the Bottom of a Pond
The Effects of Anatoxin-a on the Muscles of Danio rerio
Behavioral Effects of Parkinson’s Disease-Related Drugs in Danio rerio
The Effect of Lighting Color on the Rate of Photosynthesis
The Effects of Sulfate and Sulfate-Free Shampoos on Dancers’ Hair
Testing the Effect of Sugar on Ants
Launching a Thrust Vectoring Rocket That Utilizes PID Control
Haoa Vanderhoop Determining if Carassius auratus Has Temperature Preferences
Dominic Zuluaga What Type of Plastic Waxworms Eat the Most




Thank you to all our Science & Engineering Fair sponsors!

Good Luck, Future Scientists and Engineers Make Some Magic at Falmouth Academy!
Congratulations to the future scientists and changemakers of Falmouth Academy.
Great discoveries and improvements invariably involve the cooperation ofmany minds.
- Alexander Graham Bell
CLIMATE SCIENCE FOR CHANGE
- Scott Wayne







The Marine Biological Laboratory proudly supports the oustanding work of Falmouth Academy Science and Engineering Fair participants.
Congratulations Students!
























